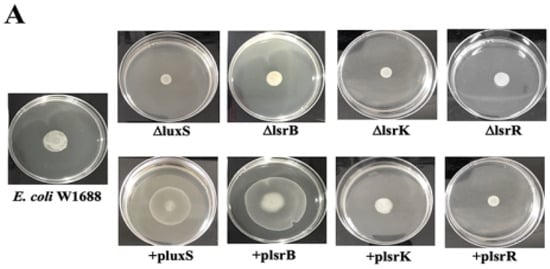

Abstract
Biofilms enable bacterial cells to adhere and thrive on surfaces, with associated changes in growth and gene expression aiding their survival in challenging environments. While previous research has explored E. coli biofilm formation, there has been limited exploration of its application in industrial production. Prior studies have shown that immobilized fermentation can enhance L-threonine production. This study aims to augment biofilm formation and subsequently increase L-threonine production in E. coli by regulating the quorum sensing system, focusing on key AI-2-related genes, including luxS, lsrB, lsrK, and lsrR. In +pluxS and +plsrB strains, AI-2 levels were significantly altered, resulting in enhanced biofilm formation, increased curli expression, shorter free-cell fermentation periods, and improved production efficiency through immobilized continuous fermentation. In a single batch of free-cell fermentation with E. coli W1688, L-threonine production was 10.16 g/L. However, +pluxS and +plsrB strains achieved L-threonine yields of 15.27 g/L and 13.38 g/L, respectively, after seven fermentation batches. Additionally, the fermentation period was reduced from 36 h to 28 h and 30 h, respectively.
1. Introduction
Biofilms are microbial communities that can adhere to biotic and abiotic surfaces by secreting extracellular polymers to enhance adhesion and aggregation []. Compared to cells in planktonic state, cells in biofilms exhibit a higher colonization capacity and tolerance to exogenous stress []. Biofilms are medically important because they are involved in many bacterial infections []. For example, Escherichia coli (E. coli) biofilm is the major causative agent for recurrent urinary tract infections [], and Staphylococcus aureus can form biofilms on the surface of medical devices and host tissues, which is the main reason for the persistence of chronic infections []. However, biofilms are also beneficial in several fields, including drinking water filtration, wastewater and solid waste treatment, biochemical production etc. []. A variety of microorganisms are present in biofilms that can absorb organic matter and pollutants. Additionally, biofilm-based fermentation performs well, with high production and efficiency, with its inherent self-fixation ability, strong resistance to adverse environments [], and the long-term maintenance of cell activity []. The biofilms of industrial strains, such as Saccharomyces cerevisiae, Aspergillus niger, E. coli, and Clostridium acetobutylicum, have been applied to produce biochemical products effectively [,,].
L-threonine, one of the eight essential amino acids, has found wide applications in food, feed, medicine, and other fields. Currently, the industrial production of L-threonine primarily relies on free-cell fermentation. E. coli is the primary strain for L-threonine production due to its well-defined genetic background and shorter fermentation period []. Nevertheless, as fermentation progresses, the recessions of cell proliferation and differentiation gradually become more serious in the industrial environment. This leads to the synthesis of by-products, accumulation of waste and a low conversion rate. The continuous (repeated-batch) fermentation of E. coli in a biofilm reactor produces a large amount of L-threonine in a shorter fermentation period than free-cell fermentation [].
Under natural conditions, biofilm formation by bacteria occurs in three distinct stages: attachment, maturation, and disintegration []. Biofilm formation is influenced by various external (such as pH, temperature, nutrients, and metal ions) and internal factors (quorum sensing (QS) molecules) [,,]. The QS system is a cell-to-cell communication mechanism that controls the expression of genes in various cellular processes [], such as virulence, luminescence, motility, sporulation, and especially biofilm formation [,]. Three main QS systems have been reported: autoinducing peptide (AIP) QS system in Gram-positive bacteria, acyl-homoserine lactone (AHL) QS system in Gram-negative bacteria, and autoinducer-2 (AI-2) QS system in both Gram-negative and Gram-positive bacteria [,,].
Among the bacteria that use AI-2 as a signal molecule, E. coli has attracted the attention of genetic engineering research since the QS system in E. coli has been well characterized [,,,]. The signal molecule AI-2 is produced by the LuxS protein, an enzyme involved in the activated methyl cycle (AMC) []. In AMC, LuxS cleaves S-ribosylhomocysteine (SRH) to yield homocysteine and 4,5-dihydroxy-2,3-pentanedione that subsequently rearranges into AI-2 []. Then, AI-2 is exported by the membrane proteins and accumulates in the extracellular space. With the increase in concentration of AI-2 during the exponential phase of growth, AI-2 is imported by the transporter LsrACDB and then phosphorylated (AI-2-P) by the kinase LsrK. The AI-2-P binds to repressor protein LsrR and relieves repression of the lsr operon, resulting in additional transcription of AI-2 uptake and processing genes [].
Previous studies have highlighted the importance of AI-2 dynamics on the E. coli QS system, including AI-2 synthesis, uptake, and phosphorylation, and its role in lsr operon expression []. However, limited studies are available on how the AI-2 QS system affects biofilm formation in E. coli. In this study, we examined the effects of modifying the four key genes (luxS, lsrB, lsrK and lsrR) in the AI-2 QS system on the biofilm formation of E. coli W1668. Changes in the gene expression were verified using quantitative real-time polymerase chain reaction (qRT-PCR). We demonstrated that overexpression of luxS and lsrB enhanced the biofilm formation of E. coli W1668 by upregulating genes that control curli synthesis. Likewise, the fermentation ability of mutants to produce L-threonine was examined, and a biofilm-based immobilized fermentation was constructed. Overall, this study presents a successful development case of transforming E. coli biofilm formation mediated by AI-2 QS system into an immobilized continuous fermentation system for the production of L-threonine.
2. Results
2.1. Growth of luxS, lsrB, lsrK, and lsrR Mutants
To determine whether the deletion or overexpression of the four key genes (luxS, lsrB, lsrK and lsrR) in an AI-2 QS system influence the growth of E. coli W1688 [], we generated strains ΔluxS, ΔlsrB, ΔlsrK, ΔlsrR, +pluxS, +plsrB, +plsrK, and +plsrR and evaluated their bacterial growth by measuring OD600 from 2 to 14 h. All mutants, including the deletion and overexpression of the key genes, showed a comparable growth rate to that of E. coli W1688 (Figure 1A,B). These results suggest that the deletion or overexpression of the four key genes has no significant effect on the growth of E. coli W1688.
Figure 1.
Growth curves of E. coli W1688 and (A) deletion and (B) overexpression mutants. The cell densities were determined by measuring OD600 at 2, 4, 6, 8, 10, 12, and 14 h.
2.2. lsrB, luxS, lsrK, and lsrR affect biofilm formation in E. coli W1688
Since the AI-2 QS plays a significant role in the biofilm formation of many bacteria [], the ability of E. coli W1688 and its mutants to form biofilm was also determined. As shown in Figure 2A, there were no significant differences between ΔlsrK, ΔlsrR, and +plsrK compared with E. coli W1688. The biofilm formation of ΔluxS and ΔlsrB decreased by 38% and 30%, respectively, while +pluxS and +plsrB displayed enhanced biofilm formation by 21% and 31%, respectively. Moreover, we observed a 33% reduction in the biofilm formation of +plsrR. The morphotypes of +pluxS and +plsrB were dry and rough, and appeared deeper pink on YESCA-CR plates as compared than E. coli W1688 and other mutants (Figure 2B), indicating increased curli fibre and biofilm formation.
Figure 2.
Ability to form biofilm and curli of E. coli W1688 and all mutants. (A) All strains were incubated in 96-well plates and subjected to CV staining assay. Absorbance at 570 nm was measured using a microplate reader. (B) All strains were inoculated on YESCA-CR plates. The colour shade of the colony combined with CR reflects the curli forming ability. p values were computed using Student’s t test (n.s., not significant at p > 0.05; * p < 0.05).
The morphology of E. coli mutants was analysed using SEM to further verify their ability to form biofilms. Results showed that +pluxS and +plsrB strains displayed substantial adhesion on coverslips and formed biofilm after 30 h incubation (Figure 3A). Meanwhile, the amount of biofilm formation was slightly reduced in both ΔluxS and ΔlsrB compared to E. coli W1688, while the other mutants showed negligible visual differences.
Figure 3.
Biofilm formation on coverslips. (A) All strains were incubated in 12-well plates with round coverslips. The cells were then collected for ethanol gradient dehydration and observed using SEM. Scale bar, 20 μm. (B) The biofilm cells on the coverslips were stained with DAPI, and the biofilm formation state was observed with a fluorescence microscope. Scale bar, 50 μm.
DAPI is a fluorescent dye that can bind strongly to DNA []. Living cells in biofilms can be observed using DAPI under a fluorescence microscope. The results of DAPI staining of all mutants on the coverslips are shown in Figure 3B. E. coli W1688 cells were highly scattered on the coverslips, whereas obvious cell aggregates appeared in +pluxS and +plsrB strains. These results suggest that the overexpression of luxS or lsrB is beneficial to the adhesion and aggregation of E. coli, which contributed to the formation of biofilms. We also found that the ΔluxS and ΔlsrB cells stained by DAPI were more scattered compared to the E. coli W1688 biofilm; the scattering was slightly reduced in ΔlsrK, +plsrK and +plsrR biofilms, and ΔlsrR biofilms did not show any significant change.
To further explore the mechanism of biofilm formation, qRT-PCR was performed to determine the expression levels of the four key genes in the AI-2 QS system and E. coli biofilm-related genes. The deletion of luxS, lsrB, lsrK, and lsrR caused a prominent decrease in the expression levels of the CSG and FIM gene families (Figure 4). In +pluxS, the expression levels of CSG genes and FIM genes were significantly upregulated (Figure 4).
Figure 4.
Biofilm-related qRT-PCR results indicating expression of genes involved in QS, adhesion, motility, and amino acid metabolism.
As the expression level of CSG family genes was significantly upregulated in +pluxS, and curli formation in E. coli is mediated by the CSG family, we examined the phenotypes of various mutants grown on YESCA-CR plates containing CR and brilliant blue. The increased curli fibre formation in +pluxS and +plsrB, denoted by a deeper shade of pink on the YESCA-CR plates (Figure 2B), was consistent with the increased expression of CSG family genes in these strains. Together, these results highlight that luxS and lsrB play an important role in the regulation of E. coli biofilm formation.
2.3. Overexpression of lsrB and luxS Affects the Motility of E. coli W1688
Effective “swarm” movement affects the colonization of E. coli at the initial stage of biofilm formation []. As shown in Figure 5A, the outer diameter of colonies formed in +pluxS and +plsrB were significantly larger than E. coli W1688, while those in ΔlsrK, ΔlsrR, +plsrK, and +plsrR strains were comparable to E. coli W1688. We further compared the diameters of the outer chemotactic ring of all mutants. The diameter of the outer chemotactic ring of E. coli W1688 was 1.7 cm. The rings of ΔluxS, ΔlsrB, ΔlsrB, ΔlsrB, +plsrK, and +plsrR were only slightly smaller than that of E. coli W1688, whereas +pluxS and +plsrB showed significant differences with outer chemotactic ring sizes of 2.9 cm and 4.1 cm, respectively.
Figure 5.
E. coli motility assay and AI-2 activity. (A) Chemotactic rings of E. coli W1688 and all mutants observed using Eiken ager plates (diameter: 7 cm). (B) Diameters of the outer chemotactic rings. (C) AI-2 activity of all strains. p values were computed using Student’s t test (n.s., not significant at p > 0.05; *** p < 0.001; ** p < 0.01; and * p < 0.05).
To explore the relationship between motility and the biofilm in more detail, the transcription levels of flhC and flhD, which are the transcriptional activators of the flagellar class II operons in E. coli, were examined. Compared with E. coli W1688, both flhC and flhD had lower expression levels in ΔluxS and ΔlsrB (Figure 4). In +pluxS, the expression levels of flhC and flhD were increased by 1.3-fold and 2.1-fold, respectively, while those in +plsrB increased by 2-fold and 4.1-fold, respectively. A downward trend was observed in the other mutants. These data were consistent with the results of swarming (Figure 5A,B).
2.4. luxS and lsrB Are Necessary for AI-2 Production and Transport in E. coli W1688
LuxS is an enzyme involved in the metabolism of SRH, producing AI-2 []. AI-2 activity was measured in E. coli W1688 and its mutants to ascertain the roles of the analysed genes in AI-2 synthesis and transport. As shown in Figure 5C, compared with E. coli W1688 (100%), AI-2 activity increased to 165.43% in +pluxS and decreased to 24.16% in the ΔluxS mutant. The deletion of lsrB also promoted extracellular AI-2 activity, which increased to 190.21%. A downward trend was observed in the other mutants. These results showed that luxS and lsrB are necessary for AI-2 production or transport in E. coli.
2.5. Free-Cell Fermentation of luxS, lsrB, lsrK, and lsrR Mutants
E. coli W1688 and the corresponding luxS, lsrB, lsrK and lsrR mutants were subjected to free-cell fermentation to observe the production of L-threonine in each strain. As shown in Figure 6A, in a single batch of free-cell fermentation, E. coli W1688 showed a high production of L-threonine (10.16 g/L, fermentation period: 36 h). Unfortunately, the luxS mutants showed decreased L-threonine production (ΔluxS, 9.36 g/L, fermentation period: 42 h; +pluxS, 8.92 g/L, fermentation period: 30 h) compared to E. coli W1688. Likewise, lsrB mutants exhibited decreased L-threonine production (ΔlsrB, 9.12 g/L, fermentation period: 39 h; +plsrB, 8.83 g/L, fermentation period: 33 h) (Figure 6B). As shown in Figure 6C, compared to E. coli W1688, ΔlsrK and +plsrK showed a lower fermentation ability. ΔlsrK produced 9.32 g/L L-threonine during 36 h of fermentation, and +plsrK produced 7.67 g/L L-threonine during 42 h. As expected, lsrR also did not show significant L-threonine production (ΔlsrR, 7.45 g/L, fermentation period: 36 h; +plsR, 7.89 g/L, fermentation period: 42 h) (Figure 6D).
Figure 6.
L-threonine production and glucose consumption in free-cell fermentation by E. coli W1688 and all mutants. Free-cell fermentation result of (A) luxS mutants, (B) lsrB mutants, (C) lsrK mutants, and (D) lsrR mutants.
2.6. qRT-PCR Analysis of the Free-Cell Fermentation of luxS, lsrB, lsrK, and lsrR Mutants
To examine the free-cell fermentation results of all strains, qRT-PCR was used to analyse the expression levels of the key genes related to biofilm and L-threonine metabolism (Figure 4). Figure 7 shows a schematic diagram of the genes and steps involved in the regulation of biofilm formation and L-threonine metabolism by E. coli AI-2 QS.
Figure 7.
Schematic diagram of AI-2 QS-mediated regulation of E. coli W1688 biofilm formation and L-threonine metabolism.
In the +pluxS strain, the expression of three glycogen synthases, glgA, glgC, and glgP, were upregulated by 2.7-fold, 4-fold, and 2.4-fold, respectively. The CSG family genes encoding curli and the FIM family genes encoding type I fimbriae were also upregulated (csgA 3.1-fold, csgB 3.3-fold, csgC 5.6-fold, csgD 2.7-fold, fimA 1.7-fold, fimH 1.7-fold). Likewise, metB and metC, which are related to methionine metabolism, were also upregulated by 2.7-fold and 1.7-fold, respectively. In addition, thrA, thrB, and thrC, which are associated with L-threonine transport to the extracellular compartment, were also slightly upregulated (1.4-fold, 1.7-fold, and 2.6-fold, respectively). The higher expression of glycogen synthase suggested a faster rate of glucose utilization and a shorter fermentation period. However, the upregulation of genes related to curli fibres and type I fimbriae resulted in higher biofilm formation in the +pluxS strain, which also consumed a lot of the carbon source. This observation may support the reduction in L-threonine production in +pluxS compared to E. coli W1688. Furthermore, all genes mentioned above were downregulated in ΔluxS, leading to lower rates of glycogen synthesis, longer fermentation periods, and the reduced consumption of other carbon sources, thereby decreasing the production of L-threonine compared to E. coli W1688.
In the +plsrB strain, the expression of CSG/FIM gene families were upregulated (csgA, 3.1-fold; csgB, 3.3-fold; csgC, 5.6-fold; csgD, 2.7-fold; fimA, 1.7-fold; fimH, 1.7-fold), and the three glycogen synthases were slightly upregulated by 1.2- to 1.5-fold. Contrarily, genes involved in the amino acid anabolic pathway were not significantly changed. These results indicated that the accelerated rate of glucose utilization contributed to a shorter fermentation period and carbon source diversion, leading to the decrease in L-threonine production. In contrast, in ΔlsrB, CSG family gene expression was downregulated 0.2- to 0.4-fold, fimA and fimH expression was also downregulated 0.5-fold, glgA and glgP expression by 0.5-fold and 0.4-fold, respectively, and glgC was not significantly changed, which resulted in an increased fermentation period compared to E. coli W1688. Genes related to methionine metabolism were also downregulated, with no significant changes in thrA, thrB, and thrC expression. These results suggest that ΔlsrB did not change L-threonine production in E. coli.
In +plsrK, the expression of glgA, glgP, and glgC were reduced, which led to a decline in glucose utilization rate and a prolonged fermentation period. Likewise, the expression of thrA, thrB, and thrC were slightly reduced, affecting L-threonine production.
In ΔlsrR, the expression of luxS and lsrB were upregulated by 1.8-fold and 2.2-fold, respectively, and the expression of lsrK was upregulated by 7-fold. Meanwhile, the expression of CSG genes and glycogen synthases (glgA and glgP) were downregulated. The overexpression of LsrACDB operon and LsrK may have affected the consumption of the carbon source, contributing to the reduced fermentation yield of L-threonine. In contrast, in +plsrR, the reduced expression of glgP and glgA affected glycogen synthesis, possibly leading to a prolonged fermentation period.
2.7. Immobilized Repeated-Batch Fermentation in +pluxS and +plsrB
The results presented above showed a rise in biofilm formation and shorter fermentation period in +pluxS and +plsrB. Therefore, we performed immobilized continuous fermentation using these two mutants, with E. coli W1688 as a control strain. The results of the continuous fermentation of E. coli W1688, +pluxS, and +plsrB are shown in Figure 8A–C, respectively. In E. coli W1688, L-threonine production in the first batch was 10.05 g/L, and the fermentation period was 36 h. The second batch of fermentation yielded 10.51 g/L L-threonine in 34 h. The L-threonine production and fermentation periods remained stable in the third and fourth batches. In the fifth batch, the L-threonine yield was 11.34 g/L, while the fermentation period was shortened to 33 h. The seventh batch showed a significant gain in fermentation efficiency compared to the first batch (Batch 1: 10.05 g/L; Batch 7: 11.52 g/L) and exhibited a shorter fermentation period (Batch 1: 36 h; Batch 7: 32 h). Thus, the immobilized continuous fermentation of E. coli W1688 increased the L-threonine yield by 13.38%, and the fermentation period was shortened, indicating that the biofilm-immobilized fermentation strategy could improve the production of L-threonine and the production efficiency. With +pluxS, L-threonine production in the first batch was 9.32 g/L, and the fermentation period was 30 h. Similar to E. coli W1688, the set-up was prolonged until the seventh batch of fermentation. The production of L-threonine gradually increased and remained stable in the last two batches. Finally, the production of L-threonine reached 15.27 g/L, and the fermentation period was shortened to 28 h in the last batch. We also found that the highest yield of L-threonine in +pluxS using immobilized fermentation was 71.18% higher than that in the free-cell fermentation in +pluxS, and was 50.29% higher than that of E. coli W1688 free-cell fermentation, suggesting that +pluxS had more efficient fermentative production of L-threonine compared with E. coli W1688.
Figure 8.
L-threonine production, glucose consumption, and SEM in immobilized continuous fermentation by E. coli W1688, +pluxS, and +plsrB. Immobilized continuous fermentation results of (A) E. coli W1688, (B) +pluxS, and (C) +plsrB. (D) SEM images of carrier in the immobilized fermentations of E. coli W1688, +pluxS, and +plsrB mutants using empty carrier as control.
With +plsrB, the first batch of fermentation yielded 8.72 g/L L-threonine, and the fermentation period was 33 h, which was not much different from that in the free-cell fermentation. In the second batch, the yield did not enhance significantly, but the fermentation period was shortened from 33 h to 30 h. Then, the fermentation period of succeeding batches were stable at 30 h, and the L-threonine yield increased from the third batch until the sixth and seventh batches. The final fermentation yield was 13.38 g/L, which was higher than that obtained in free-cell fermentation. Compared with the free-cell fermentation of E. coli W1688, the yield increased by 31.69%. These results demonstrate that modulating the AI-2 QS is an effective strategy to increase the yield of L-threonine and reduce the fermentation period during immobilized continuous fermentation. As shown in Table 1, overexpression of luxS also presents certain advantages compared to the L-threonine production of industrial E. coli strains in recent years. In terms of the yield of free-cell fermentation list in Table 1, the yield of E. coli W1688+pluxS reached the highest to 0.545 g/L/h and its conversion rate also presented obvious advantage.
Table 1.
Comparison of L-threonine production using different engineered E. coli strains.
2.8. SEM Analysis of Biofilm on Carrier
To analyse whether AI-2 QS could regulate biofilm formation on the carrier during the immobilized fermentation, we observed the corresponding carriers using SEM (Figure 8D). Compared to an empty carrier used as control, a biofilm was formed on the carrier during the immobilized fermentation process of E. coli W1688, and +pluxS and +plsrB strains formed more extensive biofilms on the carrier. Notably, in the SEM image, it was observed that +pluxS and +plsrB had a block structure of biofilm, while that of E. coli W1688 was not obvious.
3. Discussion
Studies on E. coli biofilms are mainly focused on their roles and applications in clinical and environmental fields. In the clinical field, the removal of biofilms is necessary owing to their pathogenicity and drug resistance. Meanwhile, it is necessary to introduce the high resistance and activity of the biofilm in the industrial field. However, as an important platform strain in industrial production, studies on biofilm formation in E. coli in relation to industrial fermentation are relatively lacking. Biofilm formation is essential to improve fermentation efficiency; thus, methods that promote the formation of biofilm and improve the rate of biofilm formation are necessary. Currently, researchers aim to analyse the mechanisms underlying biofilm formation in E. coli and develop new targets to prevent and resolve infection and pollution. Among them, quorum sensing, which is the mode of communication between cells to form biofilms, has been a research hotspot in recent years. Therefore, this study aimed to highlight the role of AI-2 QS in regulating E. coli intraspecies communication, subsequently targeting biofilm formation, and understanding its role in industrial production.
MP Delisa et al. reported that the AI-2 signalling level was linearly related to the accumulation level of protein product []. The high expression of AI-2 may be a regulatory factor that promotes the production of metabolites. To investigate the effect of AI-2 QS system on the biofilm formation of industrial L-threonine producing E. coli W1688, we knocked out or overexpressed the four key genes (luxS, lsrB, lsrK and lsrR) in AI-2 QS system to generate eight mutant strains. Then, we verified the biofilm formation ability of all mutants through CV staining assay, motility assay, SEM, and fluorescence microscopy. We found that among the mutants, luxS and lsrB exert a greater influence on biofilm formation in E. coli W1688. Since curli formation and motility in E. coli are closely linked to biofilm formation [], we also analysed the growth of curli fibres on YESCA-CR plates and the motility of colonies on 0.3% Eiken agar plates. The growth phenotypes further confirmed that the crucial influence of luxS and lsrB on E. coli W1688 biofilm formation. Previous studies in our laboratory have shown that promoting biofilm formation in E. coli is a key factor in enhancing immobilized fermentation []. Therefore, we analysed the fermentation performance of +pluxS and +plsrB as free cells and biofilm for the production of L-threonine. Surprisingly, both +plsrB and +pluxS gave lower L-threonine yields than E. coli W1688 in free-cell fermentation; however, the fermentation periods were reduced by 3 h and 6 h, respectively. Our preliminary analysis revealed that luxS overexpression could have affected the metabolic pathway of L-threonine biosynthesis, resulting in a reduced yield. In contrast, after lsrB overexpression, although L-threonine metabolism was not markedly affected, the increased expression of curli- and motility-related genes may have been responsible for reduced L-threonine production. The high expression level of glycogen synthase in both +pluxS and +plsrB indicates accelerated glucose utilization, which is probably responsible for the shortened fermentation period. In the context of immobilized fermentation, a comparative analysis was conducted between the immobilized fermentation of E. coli W1688 and that of +pluxS and +plsrB strains. After a span of seven batches, it was observed that the L-threonine yield exhibited an increase of 50.29% and 31.69% for the +pluxS and +plsrB strains, respectively. In addition, it was observed that the yields for +pluxS and +plsrB increased by 71.18% and 51.52%, respectively, in comparison to free fermentation. This highlights the benefits associated with the utilization of +pluxS and +plsrB in facilitating the process of biofilm development. Furthermore, it is noteworthy to mention that the fermentation duration for +pluxS and +plsrB was comparatively shorter in comparison to that of E. coli W1688. Based on these results, we also considered whether the simultaneous overexpression of luxS and lsrB can achieve better fermentation yields. However, we found that the ability of such a strain to produce L-threonine was significantly weaker than E. coli W1688 (data not shown); therefore, this should be elucidated in future studies. In our study, we have presented in detail the role of the AI-2 QS system in biofilm formation and developed an immobilized continuous fermentation process for L-threonine production in E. coli. Several other mechanisms underlying bacterial communication occur in nature, such as AIP in Gram-positive bacteria, AHL in Gram-negative bacteria, the AI-3 QS system in enterohemorrhagic E. coli [,], and other undiscovered signalling molecules. These are potential biofilm regulation mechanisms for industrial strains and have the latent capacity to be applied to immobilized continuous fermentation.
4. Materials and Methods
4.1. Media and Growth Conditions
The bacterial strains, plasmids and growth conditions used in this study are listed in Table 2. E. coli W1688 (CCTCC M2015233), obtained from mutated E. coli MG1655 (ATCC47076), is an L-threonine producer that has a weak ability to form biofilms. E. coli W1688 and mutants were cultured in Luria–Bertani (LB) medium (10 g/L tryptone, 5 g/L yeast extract, 10 g/L NaCl) at 37 °C. The fermentation medium contained 30 g/L glucose, 2 g/L yeast extract, 1 g/L KH2PO4, 20 g/L (NH4)2SO4, 0.8 g/L MgSO4·7H2O, 0.2 g/L FeSO4·7H2O, 0.2 g/L MnSO4·5H2O, and 15 g/L CaCO3. When necessary, 50 μg/mL kanamycin or 40 μg/mL streptomycin was added in LB medium to screen the E. coli transformants. Isopropyl-β-D-thiogalactoside (IPTG, 0.5 mM) was added to induce expression in strains containing the plasmid pET28a. L-arabinose (30 mM) was used to induce pCAS expression during CRISPR/Cas9 gene editing.
Table 2.
Strains and plasmids used in this study.
4.2. Construction of luxS, lsrB, lsrK, and lsrR Mutants
The ΔluxS, ΔlsrB, ΔlsrK, and ΔlsrR mutant strains were obtained by knocking out the target genes in E. coli W1688 using CRISPR/Cas9 gene editing technology []. Briefly, a 20 bp sequence from the target gene was selected to construct the pTarget plasmid. Then, the plasmid and repaired donor DNA were introduced into the competent E. coli W1688 containing the pCas plasmid. The transformed cells were screened to obtain the target gene deletion strain. Kanamycin and streptomycin resistance were used as selection markers to obtain the ΔluxS strain. The ΔlsrB, ΔlsrK, and ΔlsrR strains were obtained using the same gene knockout method.
The luxS, lsrB, lsrK, and lsrR genes were amplified from the genome of E. coli W1668 using the corresponding primers (Table 3). The PCR products were digested using the restriction enzymes Nco I and XhoI and ligated into the NcoI/XhoI-digested vector pET28a using the ClonExpress II one step cloning kit C112-01 (Vazyme, Nanjing, China). The constructed plasmids were transformed into E. coli W1668 using an electroporation system at 2.5 kV, 25 mF, and 200 Ω. Kanamycin (50 μg/mL) was used to screen the transformants.
Table 3.
Sequence of the oligonucleotide primers used in this study.
4.3. Growth Curves
Overnight cultures of the different strains were diluted to obtain an OD600 of 0.1 and then inoculated into fresh LB medium. At 2, 4, 6, 8, 10, 12, and 14 h, the cell densities at OD600 were measured using a microplate reader. The experiment was performed three times.
4.4. Biofilm Forming Capacity
Crystal violet (CV) staining was used to quantify biofilm formation of the different E. coli mutants []. Briefly, overnight cultures in fermentation medium were diluted to obtain an OD600 of 0.1. Then, 200 μL of diluted culture was transferred to 96-well plates (Corning, NY, USA) and incubated at 37 °C for 36 h. The wells were washed gently with 1% phosphate-buffered saline (PBS) to remove free cells. To fix the biofilms, glutaraldehyde (2.5%) was added for 20 min at 4 °C, and then the biofilms were stained with 1% CV for 20 min, washed with PBS, and air-dried. For quantification, 200 μL acetic acid was added to each well to dissolve the crystal violet, with slow shaking for 20 min. The absorbance was measured at 570 nm using a microplate reader.
Following a previously described method [], fluorescence microscopy was used to visualize adhesion properties of the bacteria and distribution of cells in biofilms. E. coli W1688 cells were stained with 4′,6-diamidino-2-phenylindole (DAPI) (Sigma, St. Louis, MO, USA) and viewed directly under a fluorescence microscope. Scanning electron microscopy (SEM) was also used to observe biofilms. Briefly, sterile round coverslips were placed in 12-well plates, then 4 mL of fermentation broth and 40 μL of different dilutions of bacterial broth were added in each well and incubated at 37 °C for 30 h. At the end of incubation, the free bacteria were gently removed and washed with sterile PBS, and then the biofilms were scraped off the round coverslips in sheets with a needle, dehydrated in an ethanol gradient (25%, 50%, 75%, 95%, and 100% for 10 min each), and finally soaked in tert-butanol for 10 min. The resulting mixture was centrifuged (5000× g at 4 °C for 5 min) to remove the tert-butanol and frozen overnight at −80 °C. Biofilm cells were dried using a FreeZone® 4.5 L Freeze Dry System (Labconco, Kansas City, MO, USA) and sputter-coated with gold. Images were acquired by using SEM (SEM 4800, Hitachi, Tokyo, Japan).
4.5. Curli Stain on YESCA-CR Plates
When grown on plates supplemented with congo red (CR), curli fibres of E. coli can be stained red, providing a convenient way to identify genes involved in curli expression []. Briefly, 2.5 μL of overnight cultures were inoculated on YESCA-CR plates, incubated at 30 °C for 48 h, and then photographed for recording. YESCA-CR plates contained 1 g/L yeast extract, 10 g/L casamino acids, and 20 g/L agar. Sterile CR (50 μg/mL) and brilliant blue (1 μg/mL) were added after autoclave sterilization of YESCA.
4.6. Motility Assay
Overnight cultures of the different strains were grown in LB medium, and then 2.5 μL of each culture was inoculated on swarming plates. The swarming motility plates contained 0.3% Eiken agar (Eiken Chemical, Tokyo, Japan), 1% tryptone, 0.5% yeast extract, 0.5% NaCl, and 0.3% glucose. The plates were dried for 3–4 h before inoculation. Then, the cultures were inoculated and photographed after 16 h incubation at 30 °C. When the assays were performed using the strains carrying pET28a, the plates also contained kanamycin.
4.7. AI-2 Detection
Vibrio harveyi BB170 cells were used to measure AI-2 activity following the method described previously []. Briefly, the different strains were centrifuged at 12,000× g at 4 °C for 10 min, and the cell-free culture fluid (CF) was obtained using filtration through 0.22 mm filter and frozen at −80 °C. V. harveyi BB170 was diluted (1:5000) in autoinducer bioassay medium [], and each CF sample was added to the diluted V. harveyi BB170 culture at 1:9 ratio. The mixture was incubated at 28 °C for 5 h. The CFs from V. harveyi BB170 and E. coli DH5α were used as the positive and negative controls, respectively. Aliquots (200 μL) were added to black 96-well plates to detect luminescence values using a multiscan spectrum in luminescence mode (SpectraMax iD5; Molecular Devices; San Jose, CA, USA). The experiment was performed in triplicates.
4.8. qRT-PCR Analysis
The analysed genes and primers used in the analysis are listed in Table 4. Briefly, E. coli cells at logarithmic phase in the fermentation medium were collected, washed twice with PBS, and then centrifuged to obtain samples for RNA extraction. Total RNA was extracted using RNAprep Pure Cell/Bacteria Kit (TianGen Biotech, Beijing, China) according to the manufacturer’s instructions. Reverse transcription was performed using the HiScript® III RT SuperMix for qRT-PCR (+gDNA wiper) (Vazyme). After reverse transcription, cDNAs were prepared for qRT-PCR. SYBR qRT-PCR Master Mix (Vazyme) was used for qRT-PCR in a StepOnePlus Real-Time PCR System (Applied Biosystems, Waltham, MA, USA). The 16S rRNA gene was used as an endogenous control to normalize the target, and gene transcription levels were determined according to the 2−⊗⊗Ct method.
Table 4.
Genes and primers used for qRT-PCR.
4.9. Free-Cell Fermentation, Immobilized Fermentation, and SEM
For free-cell fermentation, the supernatant was used to quantify L-threonine and residual sugars using high-performance liquid chromatography. For immobilized continuous fermentation, 30 g/L of carrier (a polymer porous foam consisting of polyurethane and carbon black) used in fermentation was prepared according to a previous study []. Briefly, 80% of the fermentation broth was removed after the first batch, and the remaining 20% with carrier covered with the biofilm was reserved for the next batch. After adding fresh medium, the second batch was initiated under the same conditions as above until the titre of L-threonine was stable. Subsequent batches were operated as described [].
Subsequently, the immobilized carrier with biofilm cells was harvested after fermentation and treated as described above. Images were acquired using SEM (SEM 4800, Hitachi, Japan).
L-threonine concentrations were measured using high-performance liquid chromatography (Agilent 1260 series; Hewlett-Packard, Palo Alto, CA, USA) with a UV detector, using a Sepax AAA ion exclusion column (250 × 4.6 mm; Bio-Rad Laboratories, Hercules, CA, USA), with 0.1 M sodium acetate and 80% acetonitrile as the mobile phase (1 mL/min) at 36 °C []. Before sample detection, 200 μL of the sample solution was transferred into a 1.5 mL plastic tube. Next, 100 μL of triethylamine solution and 100 μL of phenyl isothiocyanate solution were added to the tube. These components were mixed thoroughly. After allowing the mixture to react at room temperature for 1 h, 400 μL of n-hexane was added. Vortex oscillation was performed for 10 min. The mixture was left to stand for 30 min, then the phase was remove and filtered using a 0.45 μm filter membrane before taking the sample.
4.10. Statistical Analysis
All experiments were conducted at least in triplicates. Statistical significance was analysed using one- or two-way analysis of variance (ANOVA) or paired t-test with Prism software (GraphPad Prism 9.5.1 software, San Diego, CA, USA). Data are reported as the means and standard deviations of three independent experiments. p values were computed using Student’s t test (n.s., not significant at p > 0.05; *** p < 0.001; ** p < 0.01; and * p < 0.05).
5. Conclusions
In conclusion, we found that in E. coli AI-2 QS, luxS, and lsrB played a significant role in regulating AI-2 and biofilm formation. Moreover, luxS and lsrB can regulate motility and curli formation. We obtained two enhanced biofilm-forming strains by expressing luxS and lsrB and utilized them for immobilized continuous fermentations, where +pluxS showed significant results in terms of increased L-threonine production and a shortened fermentation period. Therefore, immobilized continuous fermentation may be an effective method to improve the production of bioenergy or bio-based chemicals by industrial E. coli. Our study also provides a reference value for the QS system in the efficient biofilm production of other industrial microorganisms.
Author Contributions
Conceptualization, Y.C. and W.S.; methodology, Y.Y.; validation, T.C., P.Y. and H.N.; data curation, S.S., C.L. and K.Z.; writing—original draft preparation, Y.Y. and G.L.; writing—review and editing, H.H. and W.S.; funding acquisition, Y.C., W.Z. and D.L. All authors have read and agreed to the published version of the manuscript.
Funding
This work was supported by the National Key R&D Program of China (Grant No. 2022YFC2105400; Grant No. 2021YFC2101100; Grant No. 2022YFC2104600); the National Natural Science Foundation of China (Grant No. 22178176; Grant No. 22208157); Jiangsu National Synergetic Innovation Center for Advanced Materials (SICAM); Key Research and Development Program of Nanjing Jiangbei New Area (Grant No. ZDYF20200220); Key R&D plan of Jiangsu Province (Grant No. BE2019001); and the Youth Fund of Natural Science Foundation of Jiangsu Province (Grant No. BK20220334).
Institutional Review Board Statement
Not applicable.
Informed Consent Statement
Not applicable.
Data Availability Statement
Not applicable.
Conflicts of Interest
The authors declare no conflict of interest.
References
- Fang, K.; Jin, X.; Hong, S.H. Probiotic Escherichia coli inhibits biofilm formation of pathogenic E. coli via extracellular activity of DegP. Sci. Rep. 2018, 8, 4939. [Google Scholar] [CrossRef]
- Miquel, S.; Lagrafeuille, R.; Souweine, B.; Forestier, C. Anti-biofilm activity as a health issue. Front. Microbiol. 2016, 7, 592. [Google Scholar] [CrossRef]
- Hall, C.W.; Mah, T.-F. Molecular mechanisms of biofilm-based antibiotic resistance and tolerance in pathogenic bacteria. FEMS Microbiol. Rev. 2017, 41, 276–301. [Google Scholar] [CrossRef]
- Sharma, G.; Sharma, S.; Sharma, P.; Chandola, D.; Dang, S.; Gupta, S.; Gabrani, R. Escherichia coli biofilm: Development and therapeutic strategies. J. Appl. Microbiol. 2016, 121, 309–319. [Google Scholar] [CrossRef]
- Lister, J.L.; Horswill, A.R. Staphylococcus aureus biofilms: Recent developments in biofilm dispersal. Front. Cell Infect. Microbiol. 2014, 4, 178. [Google Scholar] [CrossRef] [PubMed]
- Flemming, H.-C.; Wingender, J.; Szewzyk, U.; Steinberg, P.; Rice, S.A.; Kjelleberg, S. Biofilms: An emergent form of bacterial life. Nat. Rev. Microbiol. 2016, 14, 563–575. [Google Scholar] [CrossRef] [PubMed]
- Jiang, Y.; Liu, Y.; Zhang, X.; Gao, H.; Mou, L.; Wu, M.; Zhang, W.; Xin, F.; Jiang, M. Biofilm application in the microbial biochemicals production process. Biotechnol. Adv. 2021, 48, 107724. [Google Scholar] [CrossRef]
- Chen, T.; Liu, N.; Ren, P.; Xi, X.; Yang, L.; Sun, W.; Yu, B.; Ying, H.; Ouyang, P.; Liu, D.; et al. Efficient Biofilm-Based Fermentation Strategies for L-Threonine Production by Escherichia coli. Front. Microbiol. 2019, 10, 1773. [Google Scholar] [CrossRef]
- Yang, L.; Zheng, C.; Chen, Y.; Shi, X.; Ying, Z.; Ying, H. Nitric oxide increases biofilm formation in Saccharomyces cerevisiae by activating the transcriptional factor Mac1p and thereby regulating the transmembrane protein Ctr1. Biotechnol. Biofuels 2019, 12, 30. [Google Scholar] [CrossRef]
- Yu, B.; Zhang, X.; Sun, W.; Xi, X.; Zhao, N.; Huang, Z.; Ying, Z.; Liu, L.; Liu, D.; Niu, H.; et al. Continuous citric acid production in repeated-fed batch fermentation by Aspergillus niger immobilized on a new porous foam. J. Biotechnol. 2018, 276, 1–9. [Google Scholar] [CrossRef] [PubMed]
- Liu, D.; Chen, Y.; Li, A.; Ding, F.; Zhou, T.; He, Y.; Li, B.; Niu, H.; Lin, X.; Xie, J.; et al. Enhanced butanol production by modulation of electron flow in Clostridium acetobutylicum B3 immobilized by surface adsorption. Bioresour. Technol. 2013, 129, 321–328. [Google Scholar] [CrossRef] [PubMed]
- Sun, W.; Shi, S.; Chen, J.; Zhao, W.; Chen, T.; Li, G.; Zhang, K.; Yu, B.; Liu, D.; Chen, Y.; et al. Blue Light Signaling Regulates Escherichia coli W1688 Biofilm Formation and l-Threonine Production. Microbiol. Spectr. 2022, 10, e0246022. [Google Scholar] [CrossRef]
- Berlanga, M.; Guerrero, R. Living together in biofilms: The microbial cell factory and its biotechnological implications. Microb. Cell Fact. 2016, 15, 165. [Google Scholar] [CrossRef]
- Pan, Y.; Breidt, F., Jr.; Gorski, L. Synergistic effects of sodium chloride, glucose, and temperature on biofilm formation by Listeria monocytogenes serotype 1/2a and 4b strains. Appl. Environ. Microbiol. 2010, 76, 1433–1441. [Google Scholar] [CrossRef] [PubMed]
- Liu, L.; Yu, B.; Sun, W.; Liang, C.; Ying, H.; Zhou, S.; Niu, H.; Wang, Y.; Liu, D.; Chen, Y. Calcineurin signaling pathway influences Aspergillus niger biofilm formation by affecting hydrophobicity and cell wall integrity. Biotechnol. Biofuels 2020, 13, 1–13. [Google Scholar] [CrossRef] [PubMed]
- Rutherford, S.T.; Bassler, B.L. Bacterial quorum sensing: Its role in virulence and possibilities for its control. Cold Spring Harb. Perspect. Med. 2012, 2, a012427. [Google Scholar] [CrossRef] [PubMed]
- Waters, C.M.; Bassler, B.L. Quorum sensing: Cell-to-cell communication in bacteria. Annu. Rev. Cell Dev. Biol. 2005, 21, 319–346. [Google Scholar] [CrossRef] [PubMed]
- Wang, Y.; Yi, L.; Zhang, Z.; Fan, H.; Cheng, X.; Lu, C. Overexpression of luxS cannot increase autoinducer-2 production, only affect the growth and biofilm formation in Streptococcus suis. Sci. World J. 2013, 2013, 924276. [Google Scholar] [CrossRef] [PubMed]
- Wang, Y.; Wang, Y.; Sun, L.; Grenier, D.; Yi, L. The LuxS/AI-2 system of Streptococcus suis. Appl. Microbiol. Biotechnol. 2018, 102, 7231–7238. [Google Scholar] [CrossRef]
- Brackman, G.; Coenye, T. Quorum sensing inhibitors as anti-biofilm agents. Curr. Pharm. Des. 2015, 21, 5–11. [Google Scholar] [CrossRef]
- Banerjee, G.; Ray, A.K. Quorum-sensing network-associated gene regulation in Gram-positive bacteria. Acta Microbiol. Immunol. Hung. 2017, 64, 439–453. [Google Scholar] [CrossRef] [PubMed]
- Smith, D.; Wang, J.H.; Swatton, J.E.; Davenport, P.; Price, B.; Mikkelsen, H.; Stickland, H.; Nishikawa, K.; Gardiol, N.; Spring, D.R.; et al. Variations on a theme: Diverse N-acyl homoserine lactone-mediated quorum sensing mechanisms in gram-negative bacteria. Sci. Prog. 2006, 89, 167–211. [Google Scholar] [CrossRef]
- Xavier, K.B.; Bassler, B.L. Interference with AI-2-mediated bacterial cell–cell communication. Nature 2005, 437, 750–753. [Google Scholar] [CrossRef] [PubMed]
- Li, J.; Attila, C.; Wang, L.; Wood, T.K.; Valdes, J.J.; Bentley, W.E. Quorum sensing in Escherichia coli is signaled by AI-2/LsrR: Effects on small RNA and biofilm architecture. J. Bacteriol. 2007, 189, 6011–6020. [Google Scholar] [CrossRef] [PubMed]
- Pereira, C.S.; de Regt, A.K.; Brito, P.H.; Miller, S.T.; Xavier, K.B. Identification of functional LsrB-like autoinducer-2 receptors. J. Bacteriol. 2009, 191, 6975–6987. [Google Scholar] [CrossRef]
- De Keersmaecker, S.C.; Sonck, K.; Vanderleyden, J. Let LuxS speak up in AI-2 signaling. Trends Microbiol. 2006, 14, 114–119. [Google Scholar] [CrossRef]
- Schauder, S.; Shokat, K.; Surette, M.G.; Bassler, B.L. The LuxS family of bacterial autoinducers: Biosynthesis of a novel quorum-sensing signal molecule. Mol. Microbiol. 2001, 41, 463–476. [Google Scholar] [CrossRef]
- Stephens, K.; Zargar, A.; Emamian, M.; Abutaleb, N.; Choi, E.; Quan, D.N.; Payne, G.; Bentley, W.E. Engineering Escherichia coli for enhanced sensitivity to the autoinducer-2 quorum sensing signal. Biotechnol. Prog. 2019, 35, e2881. [Google Scholar] [CrossRef]
- Torres-Cerna, C.E.; Morales, J.A.; Hernandez-Vargas, E.A. Modeling quorum sensing dynamics and interference on Escherichia coli. Front. Microbiol. 2019, 10, 1835. [Google Scholar] [CrossRef]
- Rezzonico, F.; Duffy, B. Lack of genomic evidence of AI-2 receptors suggests a non-quorum sensing role for luxS in most bacteria. BMC Microbiol. 2008, 8, 154. [Google Scholar] [CrossRef]
- Laganenka, L.; Sourjik, V. Autoinducer 2-dependent Escherichia coli biofilm formation is enhanced in a dual-species coculture. Appl. Environ. Microbiol. 2018, 84, e02638-17. [Google Scholar] [CrossRef]
- Kapuscinski, J. DAPI: A DNA-specific fluorescent probe. Biotech. Histochem. 1995, 70, 220–233. [Google Scholar] [CrossRef]
- Partridge, J.D.; Nhu, N.T.; Dufour, Y.S.; Harshey, R.M. Escherichia coli remodels the chemotaxis pathway for swarming. mBio 2019, 10, e00316-19. [Google Scholar] [CrossRef] [PubMed]
- Xavier, K.B.; Bassler, B.L. LuxS quorum sensing: More than just a numbers game. Curr. Opin. Microbiol. 2003, 6, 191–197. [Google Scholar] [CrossRef] [PubMed]
- Zhao, H.; Fang, Y.; Wang, X.; Zhao, L.; Wang, J.; Li, Y. Increasing L-threonine production in Escherichia coli by engineering the glyoxylate shunt and the L-threonine biosynthesis pathway. Appl. Microbiol. Biotechnol. 2018, 102, 5505–5518. [Google Scholar] [CrossRef]
- Miwa, K.; Tsuchida, T.; Kurahashi, O.; Nakamori, S.; Sano, K.; Momose, H. Construction of L-threonine overproducing strains of Escherichia coli K-12 using recombinant DNA techniques. Agric. Biol. Chem. 1983, 47, 2329–2334. [Google Scholar] [CrossRef]
- Lee, K.H.; Park, J.H.; Kim, T.Y.; Kim, H.U.; Lee, S.Y. Systems metabolic engineering of Escherichia coli for L-threonine production. Mol. Syst. Biol. 2007, 3, 149. [Google Scholar] [CrossRef]
- Liu, S.; Liang, Y.; Liu, Q.; Tao, T.; Lai, S.; Chen, N.; Wen, T. Development of a two-stage feeding strategy based on the kind and level of feeding nutrients for improving fed-batch production of l-threonine by Escherichia coli. Appl. Microbiol. Biotechnol. 2013, 97, 573–583. [Google Scholar] [CrossRef]
- Liu, J.; Li, H.; Xiong, H.; Xie, X.; Chen, N.; Zhao, G.; Caiyin, Q.; Zhu, H.; Qiao, J. Two-stage carbon distribution and cofactor generation for improving L-threonine production of Escherichia coli. Biotechnol. Bioeng. 2019, 116, 110–120. [Google Scholar] [CrossRef]
- DeLisa, M.P.; Valdes, J.J.; Bentley, W.E. Quorum signaling via AI-2 communicates the "Metabolic Burden" associated with heterologous protein production in Escherichia coli. Biotechnol. Bioeng. 2001, 75, 439–450. [Google Scholar] [CrossRef] [PubMed]
- Pratt, L.A.; Kolter, R. Genetic analysis of Escherichia coli biofilm formation: Roles of flagella, motility, chemotaxis and type I pili. Mol. Microbiol. 1998, 30, 285–293. [Google Scholar] [CrossRef] [PubMed]
- Walters, M.; Sircili, M.P.; Sperandio, V. AI-3 synthesis is not dependent on luxS in Escherichia coli. J. Bacteriol. 2006, 188, 5668–5681. [Google Scholar] [CrossRef]
- Galloway, W.R.; Hodgkinson, J.T.; Bowden, S.D.; Welch, M.; Spring, D.R. Quorum sensing in Gram-negative bacteria: Small-molecule modulation of AHL and AI-2 quorum sensing pathways. Chem. Rev. 2011, 111, 28–67. [Google Scholar] [CrossRef]
- Bassler, B.L.; Greenberg, E.P.; Stevens, A.M. Cross-species induction of luminescence in the quorum-sensing bacterium Vibrio harveyi. J. Bacteriol. 1997, 179, 4043–4045. [Google Scholar] [CrossRef]
- Jiang, Y.; Chen, B.; Duan, C.; Sun, B.; Yang, J.; Yang, S. Multigene editing in the Escherichia coli genome via the CRISPR-Cas9 system. Appl. Environ. Microbiol. 2015, 81, 2506–2514. [Google Scholar] [CrossRef] [PubMed]
- Liu, L.; Wu, R.; Zhang, J.; Li, P. Overexpression of luxS promotes stress resistance and biofilm formation of Lactobacillus paraplantarum L-ZS9 by regulating the expression of multiple genes. Front. Microbiol. 2018, 9, 2628. [Google Scholar] [CrossRef]
- Collinson, S.; Doig, P.; Doran, J.; Clouthier, S.; Trust, T.; Kay, W. Thin, aggregative fimbriae mediate binding of Salmonella enteritidis to fibronectin. J. Bacteriol. 1993, 175, 12–18. [Google Scholar] [CrossRef]
- Greenberg, E.; Hastings, J.W.; Ulitzur, S. Induction of luciferase synthesis in Beneckea harveyi by other marine bacteria. Arch. Microbiol. 1979, 120, 87–91. [Google Scholar] [CrossRef]
Disclaimer/Publisher’s Note: The statements, opinions and data contained in all publications are solely those of the individual author(s) and contributor(s) and not of MDPI and/or the editor(s). MDPI and/or the editor(s) disclaim responsibility for any injury to people or property resulting from any ideas, methods, instructions or products referred to in the content. |
© 2023 by the authors. Licensee MDPI, Basel, Switzerland. This article is an open access article distributed under the terms and conditions of the Creative Commons Attribution (CC BY) license (https://creativecommons.org/licenses/by/4.0/).